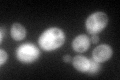
YNL015W
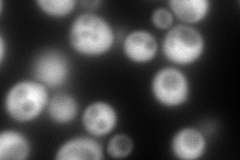
YNL015W
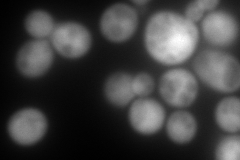
YNL015W
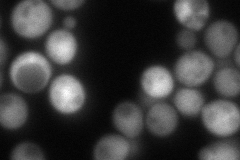
YNL015W
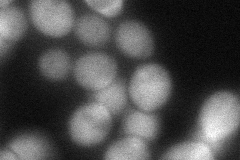
YNL015W
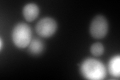
YNL015W
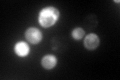
YNL015W

View description
Cytosolic inhibitor of vacuolar proteinase B, required for efficient vacuole inheritance; with thioredoxin forms protein complex LMA1, which assists in priming SNARE molecules and promotes vacuole fusion
Localization:
Intensity:
Fold change:
Significance:
-
C’ GFP library in SD
cytosol97.13 -
N' NOP1pr-GFP in SD
cytosol392.31 -
N' TEF2pr-mCherry in SD
cytosol503.867 -
N' NATIVEpr-GFP in SD
cytosol133.94 -
N' TEF2pr-VC and Cyto-VN in SD
cytosol76.1097 -
C’ GFP library in SD+DTT
cytosol366.173.76Yes -
C’ GFP library in SD+H2O2

cytosol207.652.13Yes -
C’ GFP library in Starvation Media
cytosol484.894.99Yes -
C’ GFP library on the background of Pup2-DaMP

N/A -
C’ GFP library on the background of CCT mutant

N/A0N/AYes
